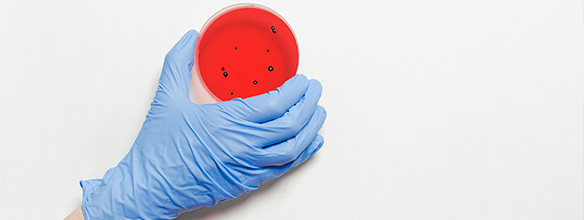
Anatomia Patològica i Citodiagnòstic +1

Graus presencials
Cicles formatius de grau superior

Higiene Bucodental

Pròtesi Dental

Ortopròtesi i Productes de Suport

Documentació i Administració Sanitàries

Imatge per al Diagnòstic i Medicina Nuclear

Laboratori Clínic i Biomèdic

Dietètica

Anatomia Patològica i Citodiagnòstic
Anatomia Patològica i Citodiagnòstic +1




